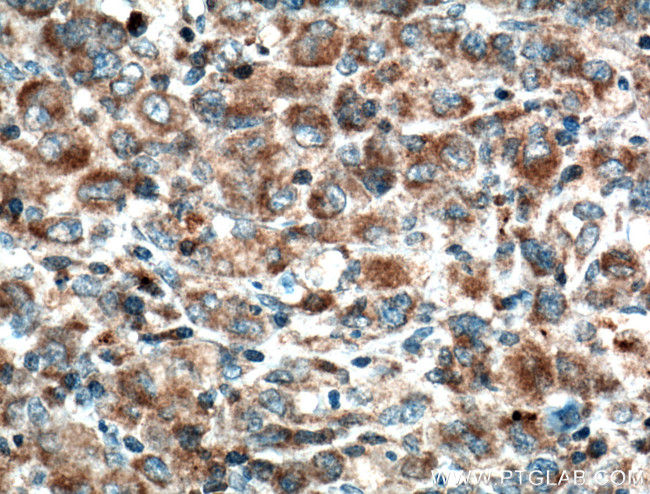
ZAP70 Antibody in Immunohistochemistry (Paraffin) (IHC (P))

Search
Proteintech
ZAP70 Monoclonal Antibody (1A11G9)
{{$productOrderCtrl.translations['antibody.pdp.commerceCard.promotion.promotions']}}
{{$productOrderCtrl.translations['antibody.pdp.commerceCard.promotion.viewpromo']}}
{{$productOrderCtrl.translations['antibody.pdp.commerceCard.promotion.promocode']}}: {{promo.promoCode}} {{promo.promoTitle}} {{promo.promoDescription}}. {{$productOrderCtrl.translations['antibody.pdp.commerceCard.promotion.learnmore']}}
产品信息
60200-1-IG
种属反应
宿主/亚型
分类
类型
克隆号
抗原
偶联物
形式
浓度
规格
纯化类型
保存液
内含物
保存条件
运输条件
产品详细信息
Immunogen sequence: STLTHPQRR IDTLNSDGYT PEPARITSPD KPRPMPMDTS VYESPYSDPE ELKDKKLFLK RDNLLIADIE LGCGNFGSVR QGVYRMRKKQ IDVAIKVLKQ GTEKADTEEM MREAQIMHQL DNPYIVRLIG VCQAEALMLV MEMAGGGPLH KFLVGKREEI PVSNVAELLH QVSMGMKYLE EKNFVHRDLA ARNVLLVNRH YAKISDFGLS KALGADDSYY TARSAGKWPL KWYAPECINF RKFSSRSDVW SYGVTMWEAL SYGQKPYKKM KGPEVMAFIE QGKRMECPPE CPPELYALMS DCWIYKWEDR PDFLTVEQRM RACYYSLASK VEGPPGSTQK AEAACA (149-493 aa encoded by BC039039)
靶标信息
ZAP-70 is a cytosolic protein tyrosine kinase that is a member of the Syk family of proteins. ZAP-70 is expressed exclusively in T-cells and natural killer cells and is required for T-cell receptor activation. Upon T cell antigen receptor (TCR) engagement, ZAP70 is phosphorylated on tyrosines 292, 315 and 319 in the interdomain B, located between the SH2 and kinase domains. Phosphorylation of both tyrosines 315 (a Vav binding site) and 319 (a Lck binding site) enhances ZAP70 function in mediating lymphocyte signaling, while tyrosine 292 terminates the transient activation of ZAP70 and attentuates lymphocyte signaling.
仅用于科研。不用于诊断过程。未经明确授权不得转售。
篇参考文献 (0)
生物信息学
蛋白别名: 70 kDa zeta-associated protein; 70 kDa zeta-chain associated protein; EC 2.7.10.2; FLJ17670; FLJ17679; kinase ZAP70; Selective T cell defect; Syk-related tyrosine kinase; Tyrosine-protein kinase ZAP-70; Tyrosine-protein kinase ZAP-70;TZK; unnamed protein product; ZA70; Zeta chain associated protein kinase 70kDa; zeta chain of T cell receptor associated protein kinase 70kDa; zeta-chain (TCR) associated protein kinase 70kDa; zeta-chain associated protein kinase, 70kD
基因别名: ADMIO2; IMD48; mrtle; mur; SRK; STCD; STD; TZK; ZAP-70; ZAP70
UniProt ID: (Human) P43403, (Mouse) P43404
Entrez Gene ID: (Pig) 100739325, (Human) 7535, (Mouse) 22637